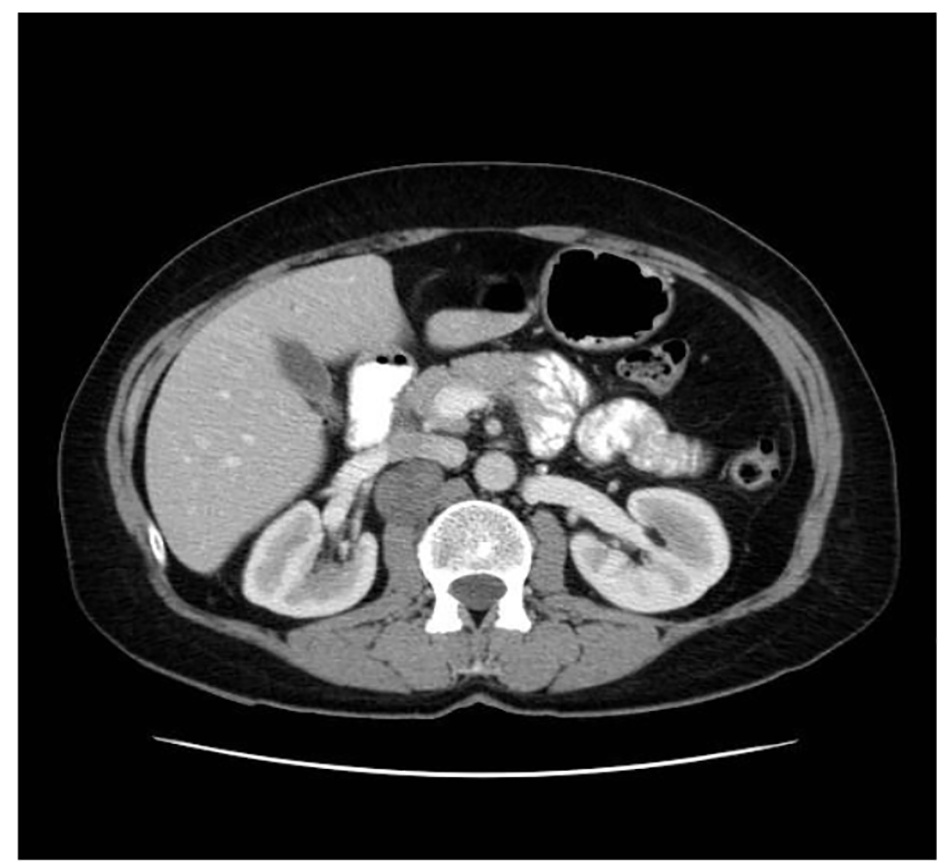

| World Journal of Nephrology and Urology, ISSN 1927-1239 print, 1927-1247 online, Open Access |
| Article copyright, the authors; Journal compilation copyright, World J Nephrol Urol and Elmer Press Inc |
| Journal website http://www.wjnu.org |
Case Report
Volume 5, Number 3, September 2016, pages 58-62
Management of Retroperitoneal Schwannoma: Case Reports and Review of the Literature
Rebeca Blanco Fernandeza, c, Luis Rodriguez Villamila, Sergio Fernandez-Pello Montesa, Begona Diaz Mendeza, Jose Manuel Pello Fonsecaa, Carmen Luz Menendezb, Corina Perez Garciaa, Rodrigo Gil Ugarteburua, Ivan Gonzalez Rodrigueza, Javier Mosquera Maderaa
aDepartment of Urology, Cabuenes Hospital, Gijon 33394, Spain
bDepartment of Pathology, Cabuenes Hospital, Gijon 33394, Spain
cCorresponding Author: Rebeca Blanco Fernandez, Department of Urology, Cabuenes Hospital, Gijon 33394, Spain
Manuscript accepted for publication September 13, 2016
Short title: Management of Retroperitoneal Schwannoma
doi: http://dx.doi.org/10.14740/wjnu277w
| Abstract | ▴Top |
Schwannoma is a rare slow-growing neurogenic tumor of the nerve sheath origin. They are commonly seen in middle-aged with a female to male ratio of 1:1.2. Here we present three cases of retroperitoneal schwannoma in our urology department. In two cases, we decided surgery management and in one case, we used watchful waiting. After a 3-year follow-up, case 1 was asymptomatic without changes in the lesion.
Keywords: Schwannoma; Retroperitoneal malignance; Neurogenic tumor
| Introduction | ▴Top |
Schwannoma is a slow-growing neurogenic tumor of the nerve sheath origin. They are commonly seen in middle-aged with a female to male ratio of 1:1.2. Visceral schwannomas are infrequent. Computerized tomography (CT) images present areas of cystic degeneration, calcification or hemorrhage. Extension of the mass along the nerve may indicate the neural origin of the mass. It is important to exclude a malignant retroperitoneal tumor to choose the correct treatment.
Here we present three cases of retroperitoneal schwannoma in our urology department.
| Case Reports | ▴Top |
Case 1
A 54-year-old female smoker presented in our department with back pain on the right. Abdominal ultrasound and CT with contrast revealed a 4.2 × 3.2 cm mass located in the retrocaval area and medial to the right kidney (Fig. 1). The findings of the images were compatible with pheochromocytoma or paraganglioma. Biochemical workup included plasma and urine catecholamine. All studies were normal. The imaging-guided biopsy was done. Microscopic findings showed a mass composed of fusiform cells with abundant collagen and spaces with macrophages. No mitoses were observed. Immunohistochemistry showed that the tumor cells were positive for S-100, BCL2, CD56, CD99 and negative for CD34 and muscle specific actin and desmin. The Ki67 activity was 1%. These findings were consistent with benign schwannoma.
![]() Click for large image | Figure 1. Abdominal CT showing a tumor occupying the retroperitoneal space. |
Because it was a benign case with small mass and the patient was asymptomatic, we decided watchful waiting with radiological periodic controls.
Case 2
A 56-year-old woman smoker was dispatched to the hematology department with thrombocytopenia after a routine health examination. Physical examination was normal. The patient presented a right flank disturbance. CT showed a right homogeneous adrenal mass of 10.8 cm diameter (Fig. 2). Laboratory tests with catecholamines and tumor marks were negative. Therefore, a functioning tumor was discarded.
![]() Click for large image | Figure 2. Abdominal CT showing an adrenal lesion. |
The patient underwent a right adrenalectomy laparoscopic surgery. Pathological evaluation revealed an adrenal schwannoma. Macroscopically tumor was well-circumscribed and encapsulated. The tumor measured 10 × 9.5 × 6 cm and weighed 427 g (Fig. 3). Histopathological findings showed regular fusiform cells, without atypia or mitosis and fibrillar cytoplasm. Intersecting cells were surrounded by histiocytes. Also there was collagen area which was stained with Masson’s trichrome (Fig. 4). Tumor cells expressed S-100 (Fig. 5), IV collagen, vimentin and GFAP. The desmin and c-kit were negative. Ki67 activity was 30%.
![]() Click for large image | Figure 3. Resected mass measuring 10 × 9.5 × 6 cm in diameter. |
![]() Click for large image | Figure 4. Hematoxylin-eosin stain: dense spindle cell proliferation with presence of vascular formations and lymphocytic infiltrates (× 100). |
![]() Click for large image | Figure 5. S-100 protein: intense and diffuse positivity (× 100). |
Case 3
A 46-year-old male smoker with rheumatoid arthritis presented with right iliac fossa pain without other symptoms. CT revealed a 5 × 3.7 cm retroperitoneal mass located in the periaortic area, down left kidney (Fig. 6). Microscopically, biopsy showed vimentin, S-100, CD56 and BCL2 positive and negative for desmin, specific muscle actine and CD34. Ki67 activity was 1%. Theses findings were compatible with benign schwannoma. Laparoscopic test was performed. The tumor had a gray-purple surface with irregular areas. It measured 6.8 × 3.5 × 3.5 cm and weighed 40 g (Fig. 7). Histopathological features were thick fibrous capsules with lymphoid nodules surrounding the tumor. Spindle cells with pale cytoplasm were arranged in fascicles. Rare cells showed enlarged hyperchromatic nuclei. Mitotic activity was low (2/10 HPF). Ki67 activity was 20%. The tumor contained lymphocytic and histocytic aggregates. Immunohistochemical analysis showed positive cells at S-100 and SOX-10 and negative for desmin, EMA CytoK CD117, and GCDFP15.
![]() Click for large image | Figure 6. Abdominal CT scan showing the retroperitoneal lesion. |
![]() Click for large image | Figure 7. Macroscopic view of a retroperitoneal schwannoma. |
| Discussion | ▴Top |
Schwannomas are neurogenic tumors which are developed by Schwann cells of peripheral nerves except cranial nerve I and II, where Schwann cells are absent. They are commonly seen in middle-aged females (2:3) [1]. The most frequent areas are cephalocervical region (44.8%), extremities and limbs (32.6%). The benign tumor is more frequent in the spinal cord (20-30%). Visceral areas for this tumor include stomach, liver, pancreas, kidney, heart and brain [2, 3]. It is associated with Cushing syndrome and Von Recklinghausen’s disease (5-8%) [4]. Percentage of patients with schwannoma and Von Recklinghausen’s disease is 5-18%. In this case, malignancy is more frequent [1, 5, 6]. None of the stigmata of this disease was present in our cases.
Retroperitoneal schwannoma represents 0.3-5% of all primary schwannomas and 1-4% of all retroperitoneal tumors [1, 3, 6, 7]. Herden et al reported 27 cases of retroperitoneal schwannoma [8]. Malignant schwannomas can also occur in the stomach, the retroperitoneum and the head, and they can also be part of the Carney complex. Malignant transformation is rare; however, in these cases, there is a high probability of local dissemination and distant metastases. The mean size of schwannoma reported by Famnurg-Smith et al was 10.2 cm [9].
Adrenal incidentaloma incidence is 4-6% in general population [2]. Schwannomas represent < 1% of all adrenal incidentalomas [1, 10]. The most important difference between adrenal schwannomas and retroperitoneal schwannomas is that the retroperitoneal schwannomas can undergo malignant transformation with poor prognostic [5]. We present the case of a middle-aged female diagnosed of adrenal schwannoma. There have been fewer than 20 reported cases in the review literature [1]. Tumor measured 10 × 9.5 × 6 cm and weighed 427 g (case 2). The average size of adrenal schwannomas which have been published is 5.5 cm with range from 0.6 to 14.5 cm and the median weight is 84 g with ranges from 31.5 to 600 g [1, 2].
Retroperitoneal schwannomas are usually discovered incidentally because retroperitoneal space is flexible and the diagnosis is often delayed, therefore, the lesion reaches significant size at time to diagnosis. The most common symptoms are abdominal pain and distention. In some rare cases, hypertension, hematuria, renal colic, urinary incontinence or sensory deficits have been reported. In our cases, abdominal discomfort was the predominant symptom.
Schwannomas often have a capsule and they are located in relation to the nerve of origin. They have homogeneous or heterogeneous appearance with areas of cystic degeneration (61-66% of cases) and calcifications (23% of cases) or hemorrhage at CT [2-7]. When CT showed a heterogeneous lesion, the tumor can mimic pheochromocytoma or other malignant tumors. Magnetic resonance imaging (MRI) using gadolinium contrast is superior to CT to define margins and identify the nerve origin. Schwannomas are hypointense on T1 and heterogeneous hyperintense on T2. These findings are characteristic but not specific of the schwannomas. Malignant schwannomas have irregular contour and tend to invade other structures. The accuracy of core needle biopsy is poor and diagnosis is usually made after the resection. Kudo et al and Strauss et al suggested using the core needle biopsy to diagnose the schwannoma with an accuracy rate of 98% to distinguish benign from malignant tumors and a accuracy rate of 81% to identify benign tumor subtypes [7, 11]. Furthermore, biopsy carries a risk of tumor seeding in case of the malignant processes [2, 12].
The differential diagnosis of non-functional adrenal masses includes adenoma, myolipoma, metastases, carcinoma and neuroblastoma. In case of adenoma and myolipoma, MRI can be used for differentiating both diagnoses, because they contain fat components. Other retroperitoneal tumors include paragangliomas, pheochromocytomas, liposarcomas, ganglioneuromas and histiocytomas. When retroperitoneal schwannoma contains cystic degeneration, hematoma and lymphangioma should be included in the differential diagnosis. The most important differential diagnoses are sarcomas: malignant peripheral nerve sheath tumor (MPNST) and leiomyosarcoma (which would appear more eosinophilic). GIST could also be considered. Synovial sarcoma is very uncommon in such location.
Definitive diagnosis is based on surgically resected specimens [8]. Macroscopically, schwannomas are a well-circumscribed solid mass attached to a peripheral nerve. Histologically, we could differentiate several types of schwannoma: ancient, cellular and plexiform. Cellular schwannoma is the most important because it is often confused with other spindle cell malignancies. The diagnosis criteria of cellular schwannoma are the presence of spindle cells with eosinophilic cytoplasm in a collagenous compact stromal with Antoni A areas (hypercellular areas) and Antoni B areas (hypocellular area). Nuclear-free zones can also be found within the regions of nuclear palisading (Verocay’s bodies). Other features suggestive of schwannoma are the presence of hyalinised vessels and infiltration of macrophages [8, 9, 12]. Adrenal schwannomas present nuclear atypia which should not be confused with malignancy.
Immunohistochemical studies show strong positive S-100 protein (specific marker to Schwann cells and melanocytes). These cases illustrate the importance of S-100 in the recognition of benign nerve sheath tumors. Schwannomas and neurofibromas diffusely express S-100 protein, whereas MPNST shows focal positivity in only 50-60% of cases. This is particular important in cellular or atypical variants of benign nerve sheath tumors such as cellular schwannoma, “atypical” neurofibromas and “ancient” schwannoma. Schwannoma is positive for SOX-10, vimentin and calretinin (differential diagnosis of neurofibroma) [3]. Pheochromocytomas are negative for S-100 and they do not present spindle cells. Glial fibrillar acidic protein (GFPA) expression is frequent in retroperitoneal schwannoma especially of the cellular type [9]. They are negative for c-kit or CD117 (present in GIST), CD34 (present in solitary fibrous tumor), specific muscle actin and desmin (present in smooth muscle tumors), smooth muscle actin and AKL from inflammatory myofibroblastic tumor, CDK4 and MDM2 for dedifferentiated liposarcoma and HMB-45 (differential diagnosis of melanoma). Ki67 index of 5-65% is suggestive of malignancy [11]. In cases 2 and 3, the Ki67 indexes were 35% and 20%, respectively. Apart from this, our patients show a benign schwannoma.
Treatment of schwannomas consists of total resection. They are not sensitive to radiotherapy and chemotherapy. Tumor recurrence or malignant transformation after complete resection is rare (5-10%) [6]. Incomplete resection may lead to local recurrence in 10-54% of cases during 6 months after resection [4]. Open or laparoscopic procedures are appropriate. Hobart et al concluded that both achieve similar results. The technique of choice could be the laparoscopic but in larger schwannomas (> 5 cm) remains controversial [2, 10]. Laparoscopic surgery reduced hospital stay, bleeding and transfusions. Complete laparoscopic resection was achieved in two of our three patients. After a 3-year follow-up, case 1 is asymptomatic without changes in the lesion. Cases 2 and 3 had no recurrences.
The management of non-functional adrenal masses depends on the size of lesion. Majority of adrenal lesions remain stable, 5-25% increase and 3-4% decrease in size. Watchful waiting is appropriate for lesions lower than 4 cm and imaging appearance of benign. Lesions greater than 4 cm should be excised. After surgical resection, some authors recommended follow-ups of 6, 12 and 18 months [2]. Curative treatments have favorable prognosis.
In asymptomatic cases or patients whose surgery poses a high risk, radiologic surveillance or radiofrequency ablation could be an option of therapy [8]. Strauss et al reported a study of eight patients undergoing a biopsy with conservative treatment. None of them have changed after 32 months of follow-up [7].
Conclusions
Schwannomas are rare tumors that may be difficult and incidentally to diagnose. Adrenal schwannoma is an uncommon cause of incidentaloma. Suspected diagnosis is made using imaging test. The features of malignant schwannomas are tumor over 5 cm, irregular contour, bleeding or intratumor necrosis or Ki67 index of 5-65%. Definitive diagnosis is based on histological analysis and immunohistochemistry plays an important role. Detecting a malignant retroperitoneal schwannoma is crucial for effective management. Conservative management would be indicated in asymptomatic patients in whom malignancy has been ruled out after guided tissue biopsy or when surgery poses a high risk. Definitive treatment is a complete resection.
| References | ▴Top |
- Grasso E, Simone M. Adrenal Schwannomas: Rare tumour of the retroperitoneum. Hindawi Publishing Corporation. 2015;1-4.
- Mohiuddin Y, Gilliland MG. Adrenal schwannoma: a rare type of adrenal incidentaloma. Arch Pathol Lab Med. 2013;137(7):1009-1014.
doi pubmed - Adas M, Ozulker F, Adas G, Koc B, Ozulker T, Sahin IM. A rare adrenal incidentaloma: adrenal schwannoma. Case Rep Gastroenterol. 2013;7(3):420-427.
doi pubmed - Vijayan SK, Shetty S, Bhat SR, Khadilkar UN. Retroperitoneal schwannoma: an atypical presentation. J Clin Diagn Res. 2014;8(10):ND22-23.
pubmed - Kalayci M, Akyuz U, Demirag A, Gurses B, Ozkan F, Gokce O. Retroperitoneal schwannoma: a rare case. Case Rep Gastrointest Med. 2011;2011:465062.
doi - Fu H, Lu B. Giant retroperitoneal schwannoma: a case report. Int J Clin Exp Med. 2015;8(7):11598-11601.
pubmed - Strauss DC, Qureshi YA, Hayes AJ, Thomas JM. Management of benign retroperitoneal schwannomas: a single-center experience. Am J Surg. 2011;202(2):194-198.
doi pubmed - Herden J, Drebber U, Ural Y, Zimmer S, Wille S, Engelmann UH. Retroperitoneal schwannomas of renal and pararenal origin: presentation of two case reports. Rare Tumors. 2015;7(1):5616.
doi pubmed - Hirose T, Ishizawa K, Sakaki M, Fujii Y. Retroperitoneal schwannoma is characterized by a high incidence of cellular type and GFAP-immunoreactivity. Pathol Int. 2012;62(7):456-462.
doi pubmed - Richter KK, Premkumar R, Yoon HS, Mercer P. Laparoscopic adrenalectomy for a rare 14-cm adrenal schwannoma. Surg Laparosc Endosc Percutan Tech. 2011;21(6):e339-343.
doi pubmed - Kudo T, Kawakami H, Kuwatani M, Ehira N, Yamato H, Eto K, Kubota K, et al. Three cases of retroperitoneal schwannoma diagnosed by EUS-FNA. World J Gastroenterol. 2011;17(29):3459-3464.
pubmed - Khandakar B, Dey S, Chandra Paul P, Medda S, Bhattacharya A, Datta S. Retroperitoneal giant ancient schwannoma. Arch Iran Med. 2014;17(12):847-849.
pubmed
This is an open-access article distributed under the terms of the Creative Commons Attribution-NonCommercial 4.0 International License, which permits unrestricted non-commercial use, distribution, and reproduction in any medium, provided the original work is properly cited.
World Journal of Nephrology and Urology is published by Elmer Press Inc.